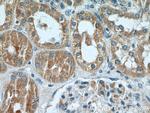
ARF3 Antibody in Immunohistochemistry (Paraffin) (IHC (P))

Search
Proteintech
ARF3 Polyclonal Antibody
{{$productOrderCtrl.translations['antibody.pdp.commerceCard.promotion.promotions']}}
{{$productOrderCtrl.translations['antibody.pdp.commerceCard.promotion.viewpromo']}}
{{$productOrderCtrl.translations['antibody.pdp.commerceCard.promotion.promocode']}}: {{promo.promoCode}} {{promo.promoTitle}} {{promo.promoDescription}}. {{$productOrderCtrl.translations['antibody.pdp.commerceCard.promotion.learnmore']}}
产品信息
10800-1-AP
种属反应
宿主/亚型
分类
类型
抗原
偶联物
形式
浓度
规格
纯化类型
保存液
内含物
保存条件
运输条件
产品详细信息
This antibody can bind ARFs for the close sequences.
Immunogen sequence: MGNIFGNLL KSLIGKKEMR ILMVGLDAAG KTTILYKLKL GEIVTTIPTI GFNVETVEYK NISFTVWDVG GQDKIRPLWR HYFQNTQGLI FVVDSNDRER VNEAREELMR MLAEDELRDA VLLVFANKQD LPNAMNAAEI TDKLGLHSLR HRNWYIQATC ATSGDGLYEG LDWLANQLKN KK (1-181 aa encoded by BC017565)
靶标信息
ADP-ribosylation factor 3 (ARF3) is a member of the human ARF gene family. These genes encode small guanine nucleotide-binding proteins that stimulate the ADP-ribosyltransferase activity of cholera toxin and play a role in vesicular trafficking and as activators of phospholipase D. The gene products include 6 ARF proteins and 11 ARF-like proteins and constitute 1 family of the RAS superfamily. The ARF proteins are categorized as class I (ARF1, ARF2, and ARF3), class II (ARF4 and ARF5) and class III (ARF6) and members of each class share a common gene organization. The ARF3 gene contains five exons and four introns.
仅用于科研。不用于诊断过程。未经明确授权不得转售。
生物信息学
蛋白别名: 35-beta calcimedin; ADP ribosylation factor 3; ADP-ribosylation factor 3; Annexin A4; Annexin IV; Annexin-4; ANX4; ANXA4; Chromobindin-4; Endonexin I; Lipocortin IV; Liver regeneration-related protein LRRG202; P32.5; PAP-II; PP4-X; small GTP binding protein; unnamed protein product
基因别名: 5430400P17Rik; Ac1-253; AI854770; ARF3
UniProt ID: (Human) P61204, (Rat) P61206, (Mouse) P61205
Entrez Gene ID: (Human) 377, (Rat) 140940, (Mouse) 11842